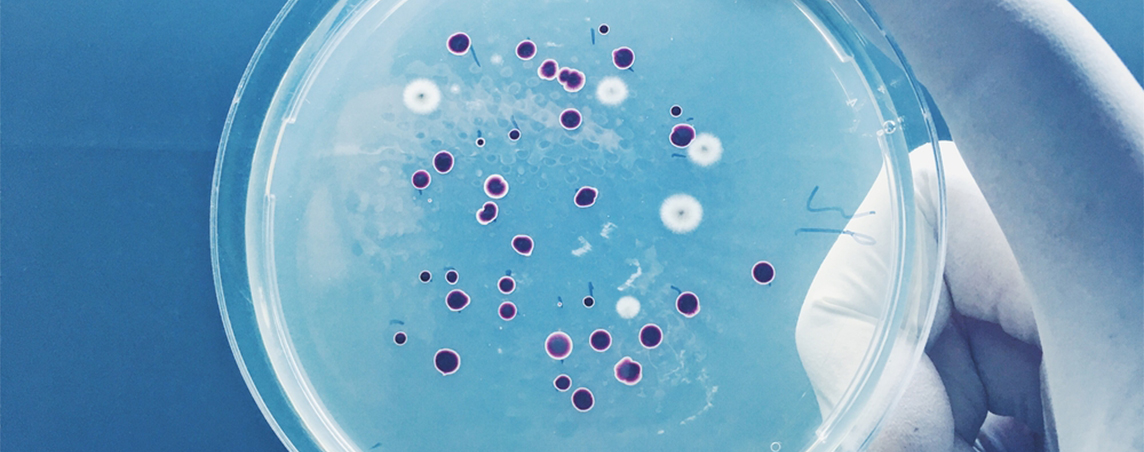
realisation/probiotiques_Xb4wffw.jpg

Packagings innovants
R&O Lab travaille depuis de longues années sur la faisabilité de diverses formules concentrées dans le but de les conditionner dans de petites capsules écologiques et économiques : Les FILLIT. C’est la concrétisation d’un magnifique projet de capsules de recharges innovantes de l’idée jusqu’à l’industrialisation.